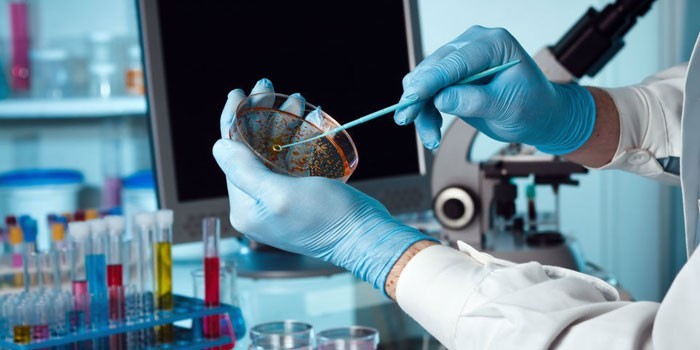
image

Комплексный анализ каловых масс позволяет оценить работу пищеварительной системы и функциональность каждого ее органа. Копрограмма является информативным методом диагностики, потому что помогает определить заболевания желудочно-кишечного тракта, уточнить локализацию нарушений, установить наличие паразитов и патогенных микробов.
Что такое копрограмма
Метод лабораторного исследования кала назначается для выявления патологий пищеварительной системы. При проведении копрограммы используются макро- и микроскопические, химические, физические анализы фекалий, делается их подробное описание. Процедура назначается для диагностики заболеваний органов пищеварения или оценки результатов проводимого лечения.
Что показывает анализ
При проведении анализа можно диагностировать такие отклонения в работе пищеварительной системы:
- нарушение работы поджелудочной железы, кишечника, желудка;
- наличие или отсутствие очагов воспаления, их локализация;
- сбой в процессе переваривания, продвижения каловых масс, всасывания питательных веществ в двенадцатиперстной и тонкой кишке;
- дисбактериоз;
- язвенный, спастический, аллергический колиты;
- наличие паразитов.
Показания к сдаче кала
Копрограмма делается ежегодно в рамках профилактического осмотра для своевременного распознавания проблем с желудочно-кишечным трактом. Также анализ показан при наличии следующих заболеваний:
- острые, хронические воспаления органов ЖКТ;
- геморрой, трещины заднего прохода;
- хронические запоры;
- цирроз печени;
- новообразования ЖКТ;
- синдром раздраженного кишечника;
- отравления;
- дисбактериоз;
- подозрения на глистную инвазию, амебную дизентерию, кишечную инфекцию;
- оценка лечения;
- до проведения инструментальной диагностики;
- колики у детей;
- муковисцидоз;
- подозрение на непереносимость лактозы.

Мнение врача:
Анализ кала на копрограмму является важной диагностической процедурой, которая позволяет врачам получить информацию о состоянии пищеварительной системы пациента. Обычно этот анализ назначается при наличии жалоб на нарушения пищеварения, боли в животе, изменениях в консистенции и цвете кала. Процедура проводится путем сбора кала пациента и последующего его исследования на содержание жиров, клетчатки, микроорганизмов и других компонентов. Полученные результаты помогают врачам определить наличие различных заболеваний желудочно-кишечного тракта, таких как дисбактериоз, гастрит, язвенная болезнь и другие. Точность и своевременность проведения анализа кала на копрограмму играют важную роль в диагностике и лечении заболеваний пищеварительной системы.

Как подготовиться к копрологическому исследованию
Запрещено сдавать кал во время месячных у женщин, при кровоточащем геморрое у взрослых. Чтобы результаты были верными, к копрограмме нужно подготовиться:
- За 5-6 дней до анализа прекратить принимать мясо, томаты, зеленые овощи, свеклу, красную рыбу – они могут показать ложноположительный результат при изучении кала на скрытую кровь.
- Включить в рацион молочную продукцию, картофельное пюре, нежирное мясо, каши, отварные яйца.
- За неделю прекратить прием активированного угля, антибиотиков, антацидов, препаратов на основе висмута, железа, противовоспалительных средств, усиливающих моторику кишечника. Запрещены слабительные, ректальные свечи, клизмы.
- Копрограмму можно делать через 5-6 суток после рентгена с барием, колоноскопии, очищающих процедур.
- Для проведения анализа желательно использовать утренний кал, но можно собрать его вечером и хранить в холодильнике в герметично закрытой емкости не дольше 10-12 часов. Для лаборатории понадобится 15-20 г материала. При сборе нужно проследить, чтобы в кал не попала моча.
Статьи по теме
- Анализ кала на скрытую кровь – как правильно сдавать и подготовка
- Анализ на дисбактериоз у ребенка и взрослого – как правильно сдать
- Копростаз у детей – кишечная непроходимость
Забор кала у ребенка
Сбор биоматериала проводится утром сразу после туалета. Нужно забрать кал из разных частей фекалий, сложить в стерильную тару или одноразовый контейнер. Опорожнение должно быть естественным, под запретом слабительные и клизмы. У грудничков нельзя собирать кал с памперса, лучше использовать одноразовую пеленку или клеенку при жидком стуле. Ребенку постарше готовят горшок, моют его с мылом или содой.

Интересные факты
-
Копрограмма – это комплексный анализ кала, который позволяет оценить функцию пищеварительной системы и выявить различные заболевания желудочно-кишечного тракта. Анализ включает в себя микроскопическое исследование, которое позволяет выявить наличие паразитов, бактерий, грибов и других микроорганизмов, а также макроскопическое исследование, которое оценивает цвет, консистенцию, запах и другие параметры кала.
-
Копрограмма часто назначается в качестве рутинного обследования при подозрении на пищевую непереносимость, синдром раздраженного кишечника, воспалительные заболевания кишечника и другие заболевания желудочно-кишечного тракта. Также анализ может быть назначен для оценки эффективности лечения или для мониторинга состояния пациента с хроническими заболеваниями пищеварительной системы.
-
Для проведения анализа кала на копрограмму необходимо собрать образец кала в чистую контейнер и доставить его в лабораторию в течение 24 часов. Результаты анализа обычно готовы в течение 1-2 рабочих дней.

Расшифровка копрограммы
Результаты копрограммы получают через 1-3 дня, но иногда их делают быстрее – за несколько часов. Расшифровкой занимается проктолог или терапевт. В анализах учитываются микроскопические, макроскопические и химические показатели.
Микроскопические исследования кала
При изучении этих показателей проводится микроскопия. Фекалии изучают на присутствие флоры, клеток крови:
|
Показатель |
Норма |
Отклонения от нормы |
|
Йодофильная флора |
Отсутствует. |
Наличие бактерий говорит о дисбактериозе. |
|
Разрушенный эпителий кишечника (детрит) |
Незначительное количество говорит о сбоях в работе пищеварения. |
|
|
Мышечные волокна |
Незначительное количество в переваренном виде. |
Неизмененный вид свидетельствует о панкреатите. |
|
Лейкоциты |
Не обнаруживаются, у грудничков в единичном количестве. |
Присутствие говорит о воспалительных процессах. |
|
Эритроциты |
В единичном количестве. |
Большой объем свидетельствует о колите, язвах, анальных трещинах, геморрое. |
|
Дрожжевые грибы |
Не выявлены. |
Присутствие говорит о дисбактериозе. |
Химические
При проведении исследований такого типа используются реактивы. Они помогают обнаружить остатки белков, жирных кислот, крахмала, волокон в фекалиях:
|
Показатель |
Норма |
Отклонения от нормы |
|
Кислотность |
6,8-7,6. |
Больше 8,5 – гнилостные процессы, 8-8,5 – нарушения работы тонкой кишки и желудка, 5,5-6,7 – нарушение процесса всасывания жирных кислот, меньше 5,5 – бродильные процессы. |
|
Растворимый белок |
Отсутствует. |
Положительные значения говорят о панкреатите, воспалениях, язве, проктите, полипах, злокачественных опухолях. |
|
Стеркобилин |
Положительный, 75-350 мг. |
Отрицательная реакция показывает на закупоривание камнями желчевыводящих протоков. При увеличении значения можно заподозрить гемолитическую анемию. |
|
Реакция на билирубин |
Отрицательная, до 3 месяцев положительная. |
Отклонение говорит о дисбактериозе, обострении гастроэнтерита. |
|
Крахмал |
Не наблюдается. |
Кристаллы присутствуют при гастрите, хроническом панкреатите, синдроме мальабсорбции. |
|
Мыло (остатки переваренных жиров) |
Незначительное количество. |
Сбой в процессе переваривания, камни в желчном пузыре, панкреатит. |
|
Жирные кислоты |
Не выявлены. |
Появляются при быстром продвижении пищи, малом количестве желчи, нарушении ее оттока. |
|
Нейтральные жиры (триглицериды) |
Нет, у грудничков в незначительном количестве. |
Нарушение синтеза желчи, ее перемещения в тонкую кишку. |
|
Растительная клетчатка, растворимые, нерастворимые соединительнотканные волокна |
Не обнаружены. |
Низкое содержание соляной кислоты, пониженная кислотность желудочного сока, недостаток ферментов, воспалительные процессы. |
|
Аммиак |
20-40 моль/кг. |
Увеличение говорит о гнилостных процессах, воспалении в кишечнике. |
Макроскопические
При изучении этих показателей проводится визуальная оценка фекалий, органолептические исследования, для обнаружения скрытой крови применяются специальные химические реакции. Результаты и отклонения от нормы:
|
Показатель |
Норма кала |
Отклонения от нормы |
|
Цвет |
Коричневый |
Светлый – патология печени, желчных протоков, поджелудочной железы; черный – кровотечения, новообразования верхних отделов ЖКТ, язвенный колит; красноватый – кровотечения в нижних отделах кишечника. |
|
Консистенция |
Оформленный |
Мазевидный – нарушение поступления желчи, жидкий – воспаления, шарики – запор, лентовидный – спазмы сфинктера, патологии сигмовидной, прямой кишки. |
|
Запах |
Характерный |
Без запаха – запор, прием антибиотиков; прогорклого масла – сбой работы поджелудочной железы; сероводорода – язвенный колит; кислый – брожение. |
|
Кровь |
Отсутствует |
Язвы, опухоли, гельминтоз, внутренние кровотечения. |
|
Слизь |
Прозрачная, незаметная |
Дизентерия, сальмонеллез, непереносимость лактозы, колит, нарушение всасывания питательных веществ. |
Опыт других людей
Анализ кала на копрограмму – это важная процедура, которая помогает врачам диагностировать различные заболевания желудочно-кишечного тракта. Люди, которым назначают этот анализ, отмечают его простоту и важность для выявления проблем со здоровьем. Проводится он путем сдачи небольшой порции кала в специальную лабораторию. Результаты анализа помогают врачам определить наличие воспалительных процессов, инфекций, патологий пищеварительной системы. Важно помнить, что подготовка к анализу играет ключевую роль в достоверности результатов, поэтому следует строго соблюдать рекомендации врача.
Где сдать анализ на копрограмму
При нарушениях работы пищеварительной системы, обнаружении отклонений кала и процедуры опорожнения кишечника от нормы необходимо обратиться к врачу. После изучения анамнеза, особенностей рациона и образа жизни пациента терапевт выписывает направление на копрограмму.
Сделать ее можно бесплатно по полису ОМС в поликлинике по месту жительства или платно в частных лабораториях по стоимости от 450 рублей. Отдельно могут оплачиваться показатели, изучаемые свыше обычных.
Видео
Внимание!
Информация, представленная в статье, носит ознакомительный характер. Материалы статьи не призывают к самостоятельному лечению. Только квалифицированный врач может поставить диагноз и дать рекомендации по лечению, исходя из индивидуальных особенностей конкретного пациента.
Частые вопросы
Когда назначают Копрограмму?
Копрограмма является первым исследованием, который назначается пациенту при предъявлении им жалоб на нарушение пищеварения. По внешнему виду каловых масс, их химической структуре, физическим характеристикам и составу микрофлоры можно оценить состояние пищеварительного тракта.
Какие болезни может выявить копрограмма?
Общеклиническое исследование кала (копрологическое исследование или копрограмма) позволяет оценить способность органов ЖКТ переваривать пищу. В результате копрологического исследования могут быть обнаружены признаки нарушения функции печени, поджелудочной железы, тонкого кишечника и т. д.
Как правильно сдать анализ кала на копрограмму?
Контейнер стерилен, не требует предварительной обработки и полностью готов к использованию. Собирать кал следует утром – после естественной дефекации. Подготовка пробы заранее не допускается. Замораживание или хранение пробы в холодильнике не допускается.
Когда нельзя сдавать Копрограмму?
АНАЛИЗ БИОМАТЕРИАЛА НА СКРЫТУЮ КРОВЬ Отмените прием препаратов, разжижающих кровь. Алкоголь перед сдачей также противопоказан. Пробу нельзя сдавать во время месячных, продолжительных запоров и геморроя — тогда присутствие крови в фекалиях может выявить неверный результат.
Полезные советы
СОВЕТ №1
Если вам было назначено сдать анализ кала на копрограмму, следуйте рекомендациям врача относительно диеты и приема лекарств. Это поможет получить более точные результаты и избежать ложных выводов.
СОВЕТ №2
При сборе образца кала обратите внимание на правила гигиены. Важно использовать специальный контейнер, тщательно закрыть его после сбора и доставить в лабораторию как можно быстрее.
СОВЕТ №3
Если у вас возникли вопросы относительно процесса сдачи анализа кала на копрограмму, не стесняйтесь обратиться к медицинскому персоналу. Они смогут предоставить вам необходимую информацию и помочь собрать образец правильно.
